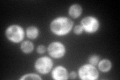
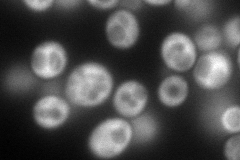
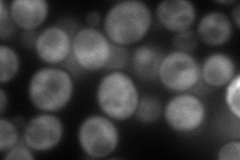
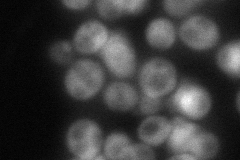

View description
Cytoplasmic RNA-binding protein that associates with translating ribosomes; involved in heme regulation of Hap1p as a component of the HMC complex, also involved in the organization of actin filaments; contains a La motif
Localization:
Intensity:
Fold change:
Significance:
-
C’ GFP library in SD
cytosol276.1 -
N' NOP1pr-GFP in SD
cytosol197.966 -
N' TEF2pr-mCherry in SD
cytosol148.659 -
N' NATIVEpr-GFP in SD
cytosol95.672 -
N' TEF2pr-VC and Cyto-VN in SD

cytosol75.6499 -
C’ GFP library in SD+DTT

cytosol252.590.91No -
C’ GFP library in SD+H2O2

cytosol252.590.91No -
C’ GFP library in Starvation Media

cytosol50.620.18Yes -
C’ GFP library on the background of Pup2-DaMP

cytosol -
C’ GFP library on the background of CCT mutant

cytosol317.7871.15098No
